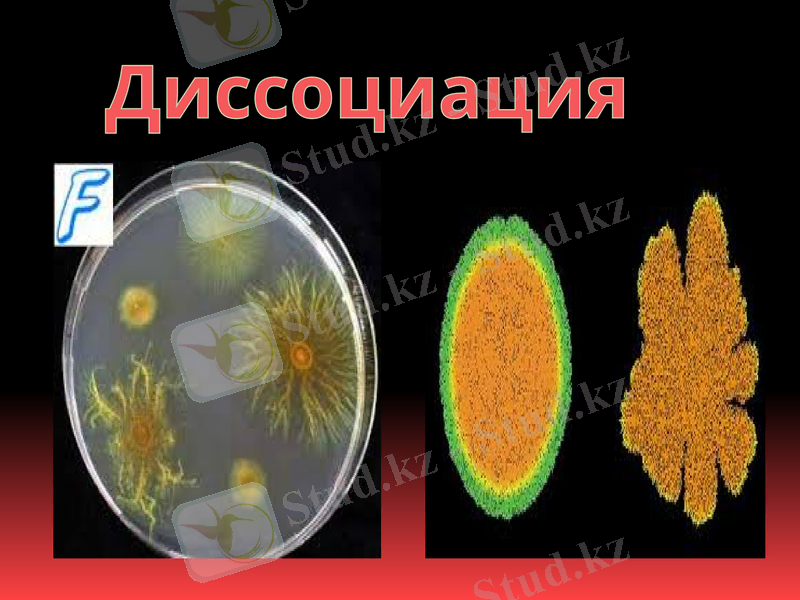
Slide 5
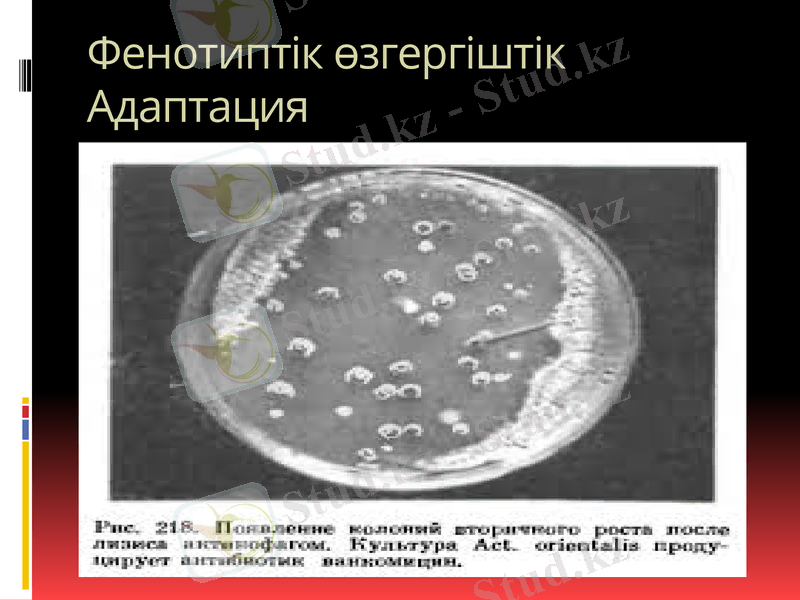
Slide 6

Микроорганизмдердің модификациясы мен диссоциациясы: фенотиптік өзгергіштік пен адаптация



Микроорганизмдердің өзгеру түрлері
Модификация диссоциация

Микроорганизмдер өзгеруі
Организмді қоршап тұрған ортаның өзі де құбылмалы болғандықтан осындай жағдайда тіршілік ететін микроорганизмдердің физиологиялық және биохимиялық қасиеттері де өзгеріске ұшырап отырады. Егерде бұл орта біршама тұрақты болса, пайда болған қасиетте микроорганизмдерде бекіп, бірқатар уақыттай сақталады. Бұның өзі микроорганизмдердің жаңа өзгерген ортаға бейімделуінде зор маңызы бар жағдай. ғалымдар микроорганизмдердің пайдалы қа-сиеттерін одан әрі жетілдіріп, алынатын өнімнің сапасын және санын арттыруға бағытталған зерттеулер жүргізуде. Қазіргі кезде түрлі әдістерді қолдана отырып, алдын-ала жасалған жоспар бойынша белгілі бір пайдалы қасиеті бар микроорганизмдерді сұ-рыптап алуға жол ашылды. Бұны селекция - сұрыптау әдістерін қолдана отырып жүзеге асыруға болады. Қазіргі кезде микроорганизмдер клеткасының құрылысы біршама жақсы зерттелді. Оның тұқым қуалаушылық қасиеті клеткадағы дезоксирибонуклеин қышқылына (ДНК) байланысты екені анықталды. ДНК-ны тұқым қуалаушылықтың материалдық негізі деп атайды. Ол тұқым қуалаушылықты бағыттайтын және бақылайтын фактор. Демек ол тіршілік кілті десек те қателеспейміз.

Диссоциация

Микроорганизмдер диссоциациясы
Лаборатория жағдайында таза микроорганизмдер топтарының өзгергіштігі байқалады. Оны бактериялар диссоциациясы деп атайды. Диссоциация барысында микроорганизмдердің әр түрлі белгілерінің езгеруі мүмкін. Осындай микроорганизмдерді қатты қоректік ортаға сепкенде морфологиялық жағынан бір-бірінен айырмашылығы бар екі типті колония түзіледі. 1. 5 - типті (ағылшынша Зтооіһ - тегіс) -тегіс, мөлдір, ептеп шырышталған, ылғалды және жиектері тегіс дөңгелек колониялар. 2. К - типті (ағылшынша Кои^һ - қыртысты) - құрғақтау, пішіні және шеттері тегіс емес колониялар. Көптеген зерттеулерге қарағанда диссоциация - бакгериялар* дың әр турлі қолайсыз орта жағдайларына қайтаратын жауабы деп түсіндіріледі. Бұндай жағдайларға орта қышқылдығы, температура, радиациялық әсерлер, мутагендік заттар әсері және т. б. жатады. Мәселен, аэробты микроорганизмдерді колбаға құйылған ет-пептонды сорпада өсіргенде, оның бет жағындағы бактериялар аса қолайлы жағдайда болса, ал түбіндегі бактерияларға жағдай қолайсыз. Бір топтағы бактериялардағы әр түрлі морфологиялық және биологиялық қасиеттердің болуы да міне осы жағдайларға байланысты болады. Әдетте микроорганизмдер тіршілігі барысында өне-бойы бір жағдайда бола бермейді, олар жаңа өзгерген жағдайға да ұшырауы мүмкін. Бұнда оларда жаңа қасиет пайда болады да, ол тұқым қуалап, бекиді. Бұны адаптация дөп атайды. Бұндай жаңа жағдай ол микроорганизмдер үшін қажетті жағдайға айналады. Онсыз олар тіршілік ете алмайды
Диссоциация
Фенотиптік өзгергіштік Адаптация

Фенотиптік өзгергіштік
Модификация (фенотиптік өзгергіштік) - эволюциялық бекітілген қоршаған орта жағдайының өзгеруіне қарай жауап берілетін микроорганизмдердің бейімделу(адаптация) реакциясы. Олар микробтың тіршілік қабілеттілігін қамтамасыз етеді және тиісті фактордың әсер етуі тоқтағаннан кейін жойылады. Қысқа уақытты модификациялар тек қана бірінші буынның тіршілік ету кезінде сақталады. Ұзақ мерзімді модификациялар бірнеше ұрпақтың тіршілік ету кезінде сақталады. Негізінде фенотиптік өзгерістер, яғни модификациялар өмірбақи тұқым қуаламайды, әсер етуші фактор жойылғаннан кейін бұрыңғы қасиеттері қалпына келеді.
- Іс жүргізу
- Автоматтандыру, Техника
- Алғашқы әскери дайындық
- Астрономия
- Ауыл шаруашылығы
- Банк ісі
- Бизнесті бағалау
- Биология
- Бухгалтерлік іс
- Валеология
- Ветеринария
- География
- Геология, Геофизика, Геодезия
- Дін
- Ет, сүт, шарап өнімдері
- Жалпы тарих
- Жер кадастрі, Жылжымайтын мүлік
- Журналистика
- Информатика
- Кеден ісі
- Маркетинг
- Математика, Геометрия
- Медицина
- Мемлекеттік басқару
- Менеджмент
- Мұнай, Газ
- Мұрағат ісі
- Мәдениеттану
- ОБЖ (Основы безопасности жизнедеятельности)
- Педагогика
- Полиграфия
- Психология
- Салық
- Саясаттану
- Сақтандыру
- Сертификаттау, стандарттау
- Социология, Демография
- Спорт
- Статистика
- Тілтану, Филология
- Тарихи тұлғалар
- Тау-кен ісі
- Транспорт
- Туризм
- Физика
- Философия
- Халықаралық қатынастар
- Химия
- Экология, Қоршаған ортаны қорғау
- Экономика
- Экономикалық география
- Электротехника
- Қазақстан тарихы
- Қаржы
- Құрылыс
- Құқық, Криминалистика
- Әдебиет
- Өнер, музыка
- Өнеркәсіп, Өндіріс
Қазақ тілінде жазылған рефераттар, курстық жұмыстар, дипломдық жұмыстар бойынша біздің қор #1 болып табылады.



Ақпарат
Қосымша
Email: info@stud.kz